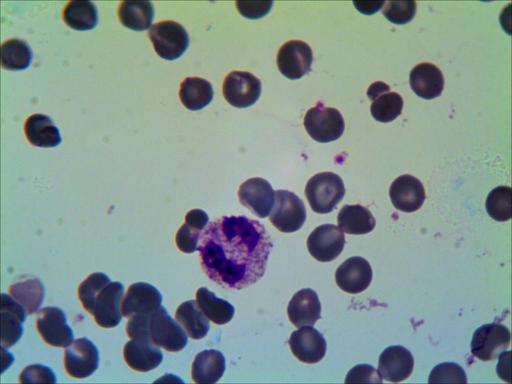
Granulocito eosinófilo-1.jpg
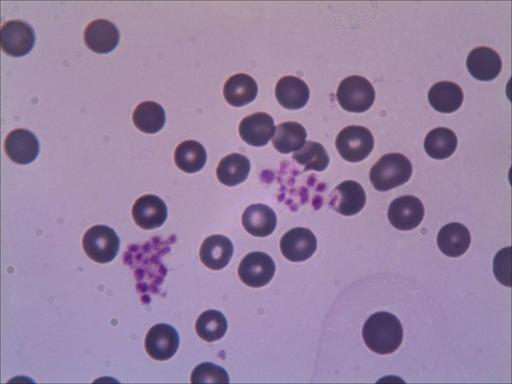
Plaquetas.jpg
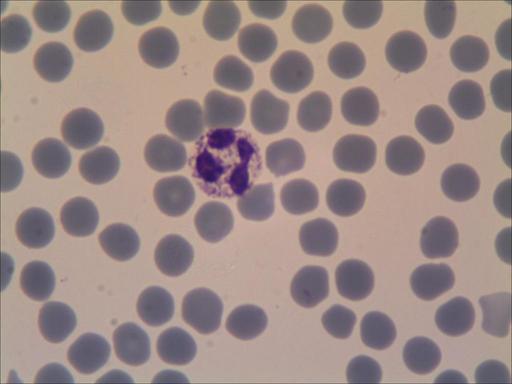
Granuocito neutrofilo-1.jpg

Página 28 de 80
Re: Fotos de análisis Coprológicos de nuestas aves.
Publicado: Sab Mar 16, 2013 10:54 pm
por Pedro J
salobreña escribió:Hola
Bueno pedro, las dos fotos centrales, estan hechas con un ocular como el tuyo, y un micro parecido.....saludos
Ya ya vamos las dos únicas que no están tan claras XD yo ya se lo que quiero ya jejejejee,saludos.
Re: Fotos de análisis Coprológicos de nuestas aves.
Publicado: Dom Mar 17, 2013 8:46 pm
por JUA
PEDRO vas viento en popa pronto tendre dos maestros jejejeje
yo de momento ya no puedo competir por decir algo, me he que dado
en inferioridad en todos los sentidos , pero bueno para dedicar a mis pajaros
de lo principal eso ya lo tengo por mano que es lo pretendía de buen principio
y seguire poniendo alguna fotillo de las mias, mas que nada para seguir al pie del cañon
estoy al dia de fotos y comentarios de tinciones que tienes con MANUEL , un saludo a todos
Re: Fotos de análisis Coprológicos de nuestas aves.
Publicado: Dom Mar 17, 2013 9:37 pm
por Pedro J
Hola JUA tu aqui con nosotros y a seguir aprendiendo eh,esos cocidios han mejorado mucho eh,es decir esas fotos,ya hace días que le pasaste la mano a alchemy jejejeje que con tanto porta y cubre que le llego y no hay manera de que ponga nada xDDD.
Re: Fotos de análisis Coprológicos de nuestas aves.
Publicado: Dom Mar 17, 2013 10:54 pm
por ALCHEMY
Joe, mañana le doy solo cañamones a uno de mis pajaros, y le dejo que le llegue la caquilla hasta el palo, a ver si enferma y puedo colgar fotos xD, Pedro que tengo los pajaros mas sanos que la dieta mediterranea, pero que si, que tienes razon, estoy algo flojo con el tema, mañana bajo al cebadero y pillo unas cacas de verdecillo, estes dias ya habia pardillos, a ver si encuentro algo rarillo en sus caquillas

Voy siguiendo el post eh, pero yo los tintes, para el pelo de la parienta

.
Un saludiño desde Galicia.
Re: Fotos de análisis Coprológicos de nuestas aves.
Publicado: Mar Mar 19, 2013 12:53 am
por salobreña
Un leucocito, limpiando la sangre de bacterias.....espectacular!!!.....saludos
[youtube]
http://www.youtube.com/watch?v=WxjNFK0oy2M[/youtube]
Re: Fotos de análisis Coprológicos de nuestas aves.
Publicado: Mar Mar 19, 2013 1:05 am
por ALCHEMY
Coñe, al final la cazo y se la comio, que pasada coño xD
Un saludiño desde Galicia.
Re: Fotos de análisis Coprológicos de nuestas aves.
Publicado: Mar Mar 19, 2013 7:26 am
por Moy Vergara
-
Re: Fotos de análisis Coprológicos de nuestas aves.
Publicado: Mar Mar 19, 2013 9:26 am
por Pedro J
Ostrassss que chulo, impresionante eh,anda Manuel dinos con que se mira eso xDDDD tiene que ser un super micro no jejejeje,saludos.
Re: Fotos de análisis Coprológicos de nuestas aves.
Publicado: Mar Mar 19, 2013 12:35 pm
por salobreña
Pedro J escribió:Ostrassss que chulo, impresionante eh,anda Manuel dinos con que se mira eso xDDDD tiene que ser un super micro no jejejeje,saludos.
Hola Pedro
Desconozco como esta hecho el video,imagino que no esta hecho directamente en el torrente sanguineo, porque tambien imagino que las celulas sanguineas de una muestra recien extraida podrian tener capacidad de respuesta para producir esas imagenes y con un micro normal y corriente, solo se necesitaria un tinte adecuado que no afecte a las celulas.......de todas formas, me parece un video al que le faltan muchos fotogramas, es decir que esta acelerado, pues pienso que si nuestro sistema inmune fuese tan rapido y efectivo, no enfermariamos nunca.
De todas formas, en una muestra de un individuo sano, dificilmente se podrian dar esas imagenes, pues para que esos diplococos del video cosigan pasar al torrente sanguineo ,la infeccion ha de ser gorda y el sistema inmune debil.
Lo que si puedes hacer para ir abriendo boca, es procurarte colorantes para ensayar la tincion Giemsa, que tiñe y distingue muy bien las celulas sanguineas......os dejo unas fotos de mis primeros pinitos con mi propia sangre, pues cuando tuve por primera vez los colorantes para la Giemsa, aprovechaba cualquier herida accidental, para hacer una muestra, pero de esto hace ya algunos años que se me paso la fiebre.....saludos

- Granulocito basofilo-1.jpg (12.65 KiB) Visto 3092 veces
- Granulocito eosinófilo-1.jpg (20.29 KiB) Visto 3093 veces

- Granuocito neutrofilo-1.jpg (18.82 KiB) Visto 3092 veces

- Linfocito-1.jpg (13.23 KiB) Visto 3093 veces
- Plaquetas.jpg (16.25 KiB) Visto 3092 veces
Re: Fotos de análisis Coprológicos de nuestas aves.
Publicado: Mar Mar 19, 2013 12:55 pm
por salobreña
JUA escribió:PEDRO vas viento en popa pronto tendre dos maestros jejejeje
yo de momento ya no puedo competir por decir algo, me he que dado
en inferioridad en todos los sentidos , pero bueno para dedicar a mis pajaros
de lo principal eso ya lo tengo por mano que es lo pretendía de buen principio
y seguire poniendo alguna fotillo de las mias, mas que nada para seguir al pie del cañon
estoy al dia de fotos y comentarios de tinciones que tienes con MANUEL , un saludo a todos
Jua,las ultimas fotos han mejorado algo, hay que seguir dando caña, madiquita el ultimo......ya sebemos que de momento el madiquita es galego.....saludos
Re: Fotos de análisis Coprológicos de nuestas aves.
Publicado: Mar Mar 19, 2013 3:10 pm
por elpollotc
salobreña escribió:Pedro J escribió:Ostrassss que chulo, impresionante eh,anda Manuel dinos con que se mira eso xDDDD tiene que ser un super micro no jejejeje,saludos.
Hola Pedro
Desconozco como esta hecho el video,imagino que no esta hecho directamente en el torrente sanguineo, porque tambien imagino que las celulas sanguineas de una muestra recien extraida podrian tener capacidad de respuesta para producir esas imagenes y con un micro normal y corriente, solo se necesitaria un tinte adecuado que no afecte a las celulas.......de todas formas, me parece un video al que le faltan muchos fotogramas, es decir que esta acelerado, pues pienso que si nuestro sistema inmune fuese tan rapido y efectivo, no enfermariamos nunca.
De todas formas, en una muestra de un individuo sano, dificilmente se podrian dar esas imagenes, pues para que esos diplococos del video cosigan pasar al torrente sanguineo ,la infeccion ha de ser gorda y el sistema inmune debil.
Lo que si puedes hacer para ir abriendo boca, es procurarte colorantes para ensayar la tincion Giemsa, que tiñe y distingue muy bien las celulas sanguineas......os dejo unas fotos de mis primeros pinitos con mi propia sangre, pues cuando tuve por primera vez los colorantes para la Giemsa, aprovechaba cualquier herida accidental, para hacer una muestra, pero de esto hace ya algunos años que se me paso la fiebre.....saludos
Granulocito basofilo-1.jpg
Granulocito eosinófilo-1.jpg
Granuocito neutrofilo-1.jpg
Linfocito-1.jpg
Plaquetas.jpg
Un poquito de anemia en esos globulos rojos eh jejejejje.
Un saludo campeones!!!!
Re: Fotos de análisis Coprológicos de nuestas aves.
Publicado: Mar Mar 19, 2013 7:58 pm
por JUA
SI MANUEL, continuare leyendo y aprendiendo de todo lo que esponeis
me ira bien para cuando me compre el otro, gracias por el video y todo lo demas
muy interesante un saludo amigos
Re: Fotos de análisis Coprológicos de nuestas aves.
Publicado: Jue Mar 21, 2013 11:05 pm
por salobreña
Hola
Os dejo un par de fotos a ver que es lo veis......los artefactos, no son el mismo ejemplar son diferentes,aunque enrealidad pudieran ser lo mismo a la hora de indentificarlos......una foto esta hecha con la camara del micro y la otra con lamera exterior.....saludos

- TS_03_20_15_09_10.JPG (18.13 KiB) Visto 3131 veces
- IMG_4104.JPG (21.22 KiB) Visto 3131 veces
Re: Fotos de análisis Coprológicos de nuestas aves.
Publicado: Jue Mar 21, 2013 11:44 pm
por elpollotc
yo creo que son gotas de grasa.
Re: Fotos de análisis Coprológicos de nuestas aves.
Publicado: Sab Mar 23, 2013 12:30 am
por salobreña
hola
No no son gotas de grasa, es otra cosa.....saludos